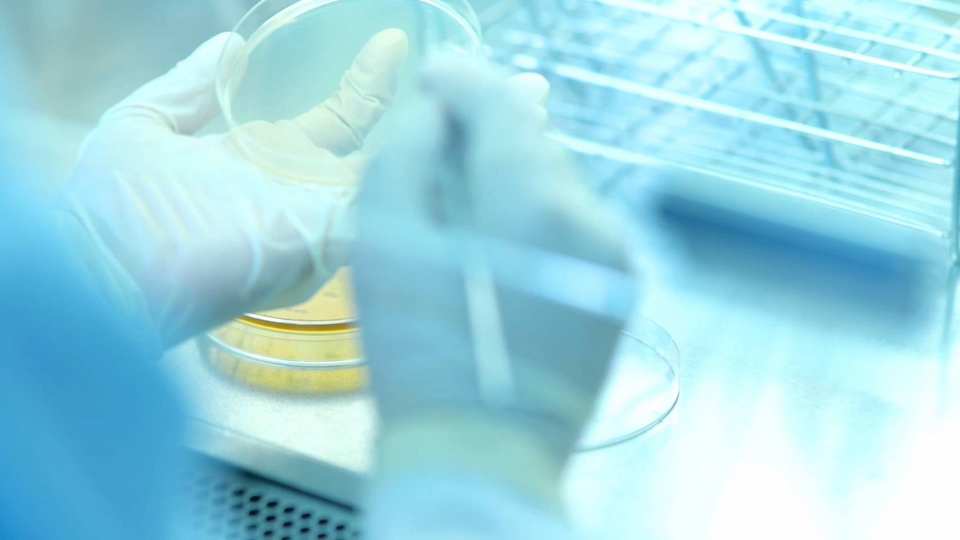

คุณลักษณะ
ซินไบโอติกชนิด
สุขภาพอาหารการประยุกต์ใช้
Bifidobacterium animalis 50มก., แลคโตบาซิลลัส paracasei 25มก., แลคโตบาซิลลัส reuteri 25มก., ผงคริกเก็ตส่วนผสมหลัก
2 ปีอายุการเก็บรักษา
แคปซูลฟอร์ม
แช่เย็นการเก็บรักษา
ความสามารถในการละลาย:ไม่ละลายน้ำ
แหล่ง:คริกเก็ต
บรรจุภัณฑ์:กล่อง
สถานที่กำเนิด:Chon Buri, Thailand
ชื่อแบรนด์:KAMISU SUPER ENTO PRODUCTS CO., LTD.
วัสดุ:Synbiotics จากผงคริกเก็ต
แพ็คเกจ:15แคปซูลต่อกล่อง
ขนาด:36.5กรัมต่อกล่อง
ระยะเวลารอคอยสินค้า:15วัน
ใบรับรอง:HACCP, GMP
ขายหน่วย:รายการเดียว





